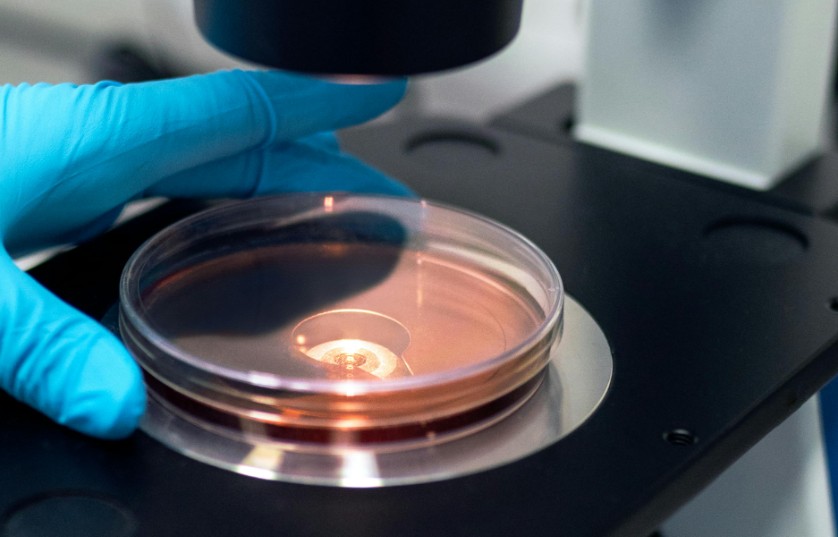

以天然为起点,三大技术平台协同驱动,专注于为全球制药及生物医药企业提供药物研发与生产服务(CRDMO)。公司深度服务创新药研发公司与药品上市许可持有人(MAHs),提供从临床早期(涵盖苗头化合物、先导化合物研究)至药品商业化生产的定制化研发(CRO)与生产(CMO)解决方案。
药物发现阶段:依托公司自主构建的高性能母核化合物库,显著加速从“苗头化合物”到“先导化合物”的研发进程。
临床前 & 临床阶段:我们提供工艺路线设计与优化、杂质谱研究与结构鉴定、分析方法开发与验证、处方前研究、处方设计与优化、工艺放大、稳定性研究、包装策略等服务。
商业化生产阶段:符合ICH指南与 cGMP 规范的商业化生产,生产规模从克级 → 公斤级 → 吨级,覆盖天然药物、小分子 API、ADC 药物、制剂等,同步提供CTD 格式注册资料撰写,助力 IND/IMPD 高效申报;提供DMF/ASMF 编写与全球注册支持。
AKTINPHARM® 制药
查看产品
制药解决方案
药物研发与生产

药物发现
我们通过建设与完善“全球药用植物活性成分开发平台”,建设天然产物化合物库,为新药筛选与研发提供活性分子库及最新的新药研发技术。

质量研究与分析服务
基于专业的分析研发、QC和QA团队,为客户提供符合申报要求的原料药、制剂、中间体以及注册原料的质量研...

原料药CRDMO
创新药和仿制药的工艺路线设计、开发及优化,提供基于QbD理念的质量研究、工艺验证、产品生命周期管理...

制剂CRDMO
基于制剂工艺开发与生产技术平台,与化学原料药CDMO协同,打造高效的制剂服务平台,包括从处方前到商业化的制剂开发和生产的全过程服务。
为客户提供制剂的CMO和CDMO服务,赋能药品上市许可持有人。
为客户提供制剂的CMO和CDMO服务,赋能药品上市许可持有人。

ADC药物开发和生产
我们提供全面且可定制的偶联服务,涵盖从早期发现、工艺优化到临床和商业化生产的各个阶段,以支持广泛偶联药物形式(XDCs)的开发,包括抗体偶联药物(ADCs)、多肽偶联药物(PDCs)以及其他新兴的生物偶联物。

注册服务
我们拥有专门的药政注册团队,为客户提供临床试验申请(IND/CTA)和临床试验不同阶段(P1、P2、P3)、新药上市申请(NDA/MAA)、仿制药上市申请(ANDA)和产品上市维护,包括产品变更、年报及再注册等服务。

